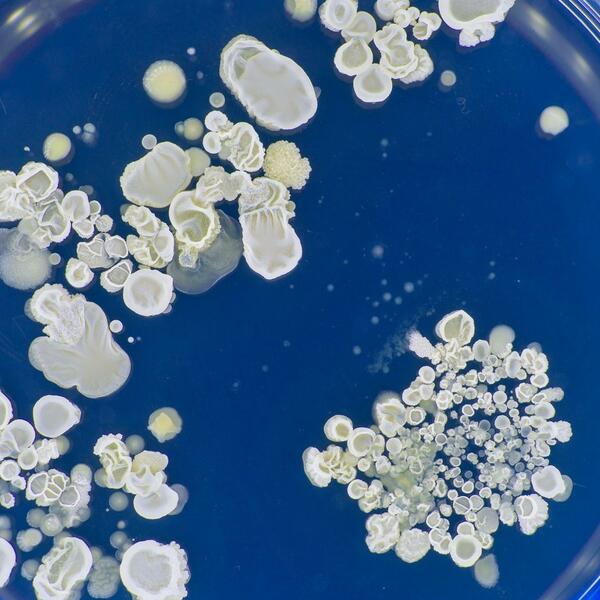

oprez
DR VOJA PERIŠIĆ UPOZORIO SVE SRBE NA OVU BAKTERIJU: "Može da dovede do SEPSE", ona se HRANI ovim NAMIRNICAMA
Gljivica kandida nalazi se svuda oko nas, ona inače uđe u organizam i prođe, ali ako kao spora pređe u živu formu, to je onda opasno
Gastroenterolog dr Vojislav Perišić tvrdi da se opasne i uporne gljivice - kandide možemo rešiti i uz pomoć ishrane. Doktor je otkrio koje namirnice pogoduju umnožavanju patogeni, a koje će ubrzati njen izlazak iz sistema. Simptomi nisu isti kod muškaraca i žena!
Kandida je jedna od najupornijih gljivica, nalazi se i u našem organizmu, i praktično svuda oko nas, a može da izazove jaku infekciju. Simptomi kandidijaze biće najpre hronični umor, bol u mišićima i nadutost, a tek onda će se javiti simptomi vidljivi golim okom, koji nisu isti kod žena i muškaraca, naročito ako imaju povišen šećer, objasnio je na TV Prva dr Perišić.
"Gljivica kandida nalazi se svuda oko nas, ona inače uđe u organizam i prođe, ali ako kao spora pređe u živu formu, to je onda opasno. Onda postaje sluznična kandidijaza, koja pravi vrlo velike probleme", rekao je gastroenterolog i objasnio koje ljude kandida vrlo retko napada.
"Postoje bakterije, virusi i gljivice kao mikropatogeni. Kandida je oportunista, ona traži pogodno tlo, neće ona na zdravog čoveka i netaknutu kožu. Ali ako postoje uslovi, nastaniće se tu. Imao sam dosta takvih pacijenata, kada se kandida nastani u jednjaku, to pravi ogromne probleme sa gutanjem", rekao je on.
Pod mikroskopom ćemo videti "pipke", odnosno hife, i onda znati da je invazivna kandida u pitanju, ali nema svako mikroskop kod kuće. Kako da onda prepoznamo, koji su simptomi kandidijaze?
"Kod muškaraca se javlja u usnoj duplji i na pregibima, pazusi, prepone, beličasta skrama je bolna, ima je i na penisu. To ćete primetiti golim okom. Kod žena je komplikovanije, ako imaju dijabetes, kandida juri pregibe i vaginalni predeo. Nezgodna je situacija ali se da lečiti", rekao je on.
Može li ishranom da se leči kandida?
"Ona voli šećer, bez slatkiša dakle, sa što manje šećera. Druga stvar, jabuka, kruška, šljiva, breskva, kajsija, ništa od toga ne sme, jer sadrži supstance koje pogoduju kandidi. Mandarine, grožđe, ananas, nemaju ih. Nije ni mleko sa laktozom zgodno, ona je isto supstrat za kandidu. Papriku i paradajz najslobodnije, a karfiol nikako. Krastavac može, brokoli ne može! Sadrže hemijska jedinjenja, neskrobne fermentabilne ugljene hidrate. Ne možete da ih svarate, oni se oslobode i spora kandide ih pronađe. Onda krene da cveta", rekao je on.
Postoji više oblika kandidijaze i jedan od njih je opasan po život, upozorio je gastroenterolog.
"Sluznična kandidijaza, probavnog ili disajnog sistema, leči se oralno. Ali sistemska je opasna, jeste relativno retka ali je vrlo gadna. Kandida može da napravi i sepsu i problem sa srcem, može da bude i fatalno, kako da ne. Kod rizičnih pacijenata se odmah pogleda ima li kandide koja može da komplikuje, onda sečemo lekovima, ne damo da tek tako ide problem", rekao je profesor.
"Začini mogu da iritiraju sluznicu, pa onda mogu da naprave ranice, e tu će doći kandida. Zato začine treba dobro dozirati, i ne preterivati. Ja koristim ljutu papričicu, ali kandidu nikad nisam imao", rekao je gastroenterolog i objasnio šta "tera" kandidu.
"Imamo ćelije sluznice i neutrofile, oni ako prepoznaju nešto strano, reagovaće. To je takozvani naivni imunitet. Ako imate redovnu stolicu i nemate bolest debelog creva, kandida će izaći. Mora se imati redovna stolica, ja jedem uveče žito i to sa šlagom. Ali brz je tranzit! I nema ugljenih hidrata koji će hraniti kandidu", rekao je on.
"Zrnevlje ne može da se razgradi zbog opne, tek kada je samlevena žitarica, svarićemo sve iz nje. Za stolicu je dobro sledeće, voće uveče, mandarine za večeru, lečio sam ženu koja je jela po pola kilograma mandarine uveče, pa imala je stolicu kao grlica posle toga", rekao je on.
"Probiotik je takođe važan ako imate kandidu, preventivno ga uzimajte u jesen i zimu. Leti se hranimo sa više vlakana. Kandida ne voli kiselost creva, svi naši sokovi su alkalni osim pljuvačke," rekao je on.
(Espreso / Alo)
Uz Espreso aplikaciju nijedna druga vam neće trebati. Instalirajte i proverite zašto!